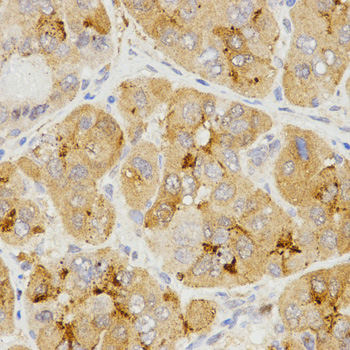

For quotations, please use our online quotation form, and you may also contact us by
service@kendallscientific.com
+1-888.733.6849 (Toll-free)
+1-617.299.7367 (Int’l))
+1-888.733.6849
Our customer service representatives are available 24 hours, Monday through Friday to assist you.| Reactivity | Human Mouse |
| Tested applications | WB IHC |
| Recommended Dilution | WB 1:500 - 1:2000 IHC 1:50 - 1:200 |
| Calculated MW | 15kDa |
| Observed MW | Refer to Figures |
| Immunogen | A synthetic peptide of human LHB |
| Storage Buffer | Store at -20℃. Avoid freeze / thaw cycles. Buffer: PBS with 0.02% sodium azide, 50% glycerol, pH7.3. |
| Synonym | CGB4;hLHB;LSH-B; |

Western blot analysis of extracts of K562 cell line, using LHB antibody.
Immunohistochemistry of paraffin-embedded human liver cancer tissue using LHB antibody at dilution of 1:200 (x400 lens)

Immunohistochemistry of paraffin-embedded human rectal cancer tissue using LHB antibody at dilution of 1:200 (x400 lens)
This gene is a member of the glycoprotein hormone beta chain family and encodes the beta subunit of luteinizing hormone (LH). Glycoprotein hormones are heterodimers consisting of a common alpha subunit and an unique beta subunit which confers biological specificity. LH is expressed in the pituitary gland and promotes spermatogenesis and ovulation by stimulating the testes and ovaries to synthesize steroids. The genes for the beta chains of chorionic gonadotropin and for luteinizing hormone are contiguous on chromosome 19q13.3. Mutations in this gene are associated with hypogonadism which is characterized by infertility and pseudohermaphroditism.
N/A